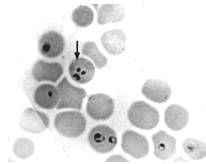

Гемоспоридіози сільськогосподарських тварин. Діагностика, поширення. Ветеринарно-санітарна оцінка продуктів забою, санітарні заходи
Національній
університет біоресурсів і природокористування України
ННІ
ветеринарної медицини та якості і безпеки продукції тваринництва
Факультет
ветеринарної медицини
Кафедра
ветеринарно-санітарної експертизи
Курсова
робота
Гемоспоридіози
сільськогосподарських тварин. Діагностика, поширення. Ветеринарно-санітарна
оцінка продуктів забою, санітарні заходи
Київ
- 2013
Зміст
гемоспоридіоз кліщ худоба мясо
Вступ
.
Гемоспоридіози тварин (Piroplasmidoses)
.1
Бабезіоз великої рогатої худоби
.2
Бабезіоз дрібної рогатої худоби
.3
Бабезіоз коней
.4
Бабезіоз свиней
.5
Тейлеріоз великої та дрібної рогатої худоби
.
Методи діагностики гемоспоридіозів
.1
Зажиттєва діагностика гемоспоридіозів
.2
Посмертна діагностика гемоспоридіозів
.3
Взяття та пересилання матеріалу для дослідження
3.
Ветеринарно-санітарна експертиза м’яса при гемоспоридіозі
4.
Профілактика та заходи боротьби
Висновки
Список
використаної літератури
Вступ
Численність видів збудників паразитарних хвороб,
різноманітність шляхів і факторів їх передачі вказують на те, що інвазії
являються небезпечними для людей і тварин, займаючи провідне місце в структурі
захворюваності, призводячи до зниження якості життя і потребуючи постійного
вдосконалення шляхів і методів боротьби з паразитарними інвазіями.
Паразитарні хвороби (фасціольоз, диктіокаульоз,
аскароз, гемоспоридіози) є причиною масової загибелі тварин, зниження
продуктивності хворих тварин. Так, падіж курей при еймеріозі може сягати 100%,
у хворих на фасціольоз корів надої молока знижуються на 25-40%, а при бабезіозі
великої рогатої худоби лактація може припинитися зовсім. У свиней, уражених
нематодами Ascaris suum, м’ясна продуктивність знижується до 30%. Погіршується
якість шкури великої рогатої худоби при паразитуванні личинок підшкірного овода
або іксодових кліщів, вовни овець - при псороптозі, меду бджіл - при ноземозі.
Нерідко виникає необхідність у вибраковуванні
уражених паразитами внутрішніх органів (печінка великої рогатої худоби при
фасціольозі та ехінококозі) або навіть усієї туші (трихінельоз свиней).
Смакові якості продукції, отриманої від хворих
тварин, погіршуються внаслідок істотного зниження вмісту в ньому амінокислот,
вітамінів, макро- й мікроелементів. При хронічному фасціольозі в молоці корів
вміст жиру може зменшуватися на 40%, загального білка та казеїну - на 15-20,
сухих речовин - на 8-12%.
Паразитарні хвороби негативно позначаються на
репродуктивних властивостях тварин, спричинюють аборти (трихомоноз великої
рогатої худоби). Молодняк від хворих тварин народжується недорозвиненим, зі
зниженою природною резистентністю. Відбувається порушення функції
імунокомпетентних органів і клітин тіла, внаслідок чого у вакцинованих проти
інфекційних хвороб тварин створюється неповноцінний імунітет.
Лікування хворих тварин пов’язане зі значними
витратами на придбання протипаразитарних лікарських засобів та їх
застосуванням.
Отже, паразитарні хвороби завдають значних
економічних збитків тваринництву в окремому господарстві, районі чи області.
Тому своєчасна їх профілактика і діагностика спеціалістами ветеринарної
медицини є одним із важливих складових у ланцюзі розробки та вдосконалення
науково обґрунтованого комплексу заходів у боротьбі з паразитарними хворобами
сільськогосподарських і домашніх тварин, птахів, бджіл, риб.
1. Гемоспоридіози тварин (Piroplasmidoses)
Гемоспоридіози - групова назва протозойних
хвороб, збудники яких належать до ряду Piroplasmida класу Sporozoa типу
Apicomplexa. До ряду Piroplasmida входить дві родини: Babesiidae з родом
Babesia і Theileriidae з родом Theileria. Хвороби, збудники яких належать до
цих родів, називають відповідно бабезіозами і тейлеріозами.
Гемоспоридіози надзвичайно поширені на всіх
континентах земної кулі. Хворіють велика рогата худоба, вівці, кози, коні,
свині, собаки, коти, а також дикі тварини. Відомі випадки захворювання на
бабезіоз людини.
Ці хвороби належать до облігатно-трансмісивних,
природно-осередкових інвазій. Біологічними переносниками збудників
гемоспоридіозів є кліщі родини Ixodidae. Збудники гемоспоридіозів
видоспецифічні як до виду тварин, так і до біологічних переносників.
Описано близько 170 видів піроплазмід, найбільша
кількість яких трапляється у парнокопитних - 41. Найбільшу кількість видів
піроплазм виявили у кліщів-переносників родів Rhipicephalus - 24, Hyalomma - 12
Haemaphysalis - 12, Dermacentor - 12, Ixodes - 5, Boophylus - 4.
Усі представники ряду Piroplasmida є
кровопаразитами хребетних тварин. Бабезії локалізуються в еритроцитах, іноді їх
виявляють у лейкоцитах та плазмі крові. Тейлерії крім еритроцитів паразитують у
лімфоцитах, моноцитах, гістіоцитах, клітинах РЕС. В еритроцитах типові форми
гемоспоридій бувають грушоподібні, кулясті, амебоподібні, комоподібні (рис. 1).
Розміри їх коливаються від 0,5 до 7 мкм. В цитоплазмі містяться ендоплазматична
сітка, рибосоми, полісоми, травні вакуолі, мітохондріальні структури. Ядро
вкрите двома мембранами. Війок і джгутиків немає. Рух амебоподібний,
здійснюється шляхом вигинання тіла або за допомогою псевдоніжок.

Рис. 1. Типові форми гемоспорид:
- Babesia bovis; 2 - Piroplasma
bigeminum; 3 - Francaiella colchica; 4 - Piroplasma caballi; 5 - Nuttallia
equi; 6 - Piroplasma canis.
Особливо поширені гемоспоридіози в
регіонах тропіків і субтропіків, а на території України - у південних областях
та Криму, де створюються сприятливі умови для розвитку переносників - іксодових
кліщів.
В Україні гемоспоридіози є
сезонними, переважно пасовищними захворюваннями, оскільки їх поширення
зумовлене наявністю кліщів-переносників, а паразитування останніх можливе лише
в теплу пору року. Більше того, в організмі кліщів гемоспоридіози можуть
зберігатись у кількох десятках поколінь і вони є резервуаром збудників.
Передавання збудників інвазії від самок кліщів потомству відбувається
трансоваріально (через яйця) або трансфазно.
Розвиток піроплазмід відбувається за
обов’язковою участю біологічних переносників - іксодових кліщів. Останні
заражаються внаслідок заковтування з кров’ю хворої тварини чи паразитоносія
збудника хвороби. В кишечнику кліща невдовзі утворюються невеликі меронти, в
яких формуються мерозоїти булавоподібної форми. Після розпаду меронтів
мерозоїти проникають в епітеліальні клітини кишечнику, де розвиваються більші
меронти. Під час розпаду останніх мерозоїти потрапляють у порожнину тіла
господаря. З гемолімфи паразити 6улавоподібної форми заносяться в слинні залози
й гонади. Розмноження бабезій у клітинах слинних залоз відбувається також
шляхом мерогонії, що призводить до утворення грушоподібних мерозоїтів,
інвазійних для хребетного господаря. В гонадах паразити уражають яйцеклітини,
внаслідок чого відбувається трансоваріальне передавання збудників.
Зараження хребетних тварин
збудниками піроплазмідозів відбувається внаслідок інокуляції в кров мерозоїтів
зі слиною кліщів. Збудники бабезіозів проникають в еритроцити, де відбувається
їх розмноження простим поділом чи брунькуванням. Після поділу ядра дочірні
клітини тривалий час не діляться, а залишаються з’єднаними тонкими
цитоплазматичними містками, утворюючи парні грушоподібні форми.
Мерозоїти тейлерій спочатку
проникають у клітини ретикулоендртельної системи (лімфатичні вузли, печінку,
селезінку), де перетворюються на трофозоїти. Останні формують меронти, або так
звані "гранатні тіла", типів: макро- і мікромеронти. У мікромеронтах
формуються мерозоїти, які проникають в еритроцити.
.1 Бабезіоз великої рогатої худоби
Хвороба спричинюється
кровопаразитами Babesia bigemina та Babesia bovis.
Характеристика збудників. B.
bigemina (син. Piroplasma bigeminum) - паразит порівняно великих розмірів (від
2,2 до 6 мкм) (рис. 2). Його довжина більша за радіус еритроцита. Трапляються
кулясті, овальні, амебоподібні, грушоподібні форми, однак характерною є
парногрушоподібна. При цьому дві груші з’єднані вузькими кінцями під гострим
кутом. У клітинах крові ці одноклітинні організми частіше локалізовані у
центральній їх частині. Ураженість еритроцитів може досягати 10-15%.

Рис. 2. Babesia bigemina в
еритроцитах.
. bovis (син. B. colchica, B.
argentina) має середні розміри (від 1,5 до 2,4 мкм). В еритроцитах можуть бути
різні форми, але типовими є парногрушоподібні, з’єднані тонкими кінцями під
тупим кутом і розміщені по периферії клітин (рис. 3). Збудник може уражати до
40%, у деяких випадках - до 70% еритроцитів.

Рис. 3. B. bovis в еритроцитах
Методи діагностики. Епізоотологічні
дані. До бабезіозу сприйнятливі всі породи великої рогатої худоби. Дорослі
тварини порівняно з молодняком хворіють у тяжчій формі. Основним переносником
збудника B. bigemina є однохазяїнний іксодовий кліщ Boophilus calcaratus (рис.
4). Меншу роль відіграють види Rhipicephalus bursa та Haemaphysalis punctata
(рис. 5, 6). Біологічними переносниками B. bovis є трихазяїнні кліщі Ixodes
ricinus (рис. 7.) і I. persulcatus.

Рис. 4. Boophilus calcaratus

Рис. 5. Rhipicephalus bursa

Рис. 6. Haemaphysalis punctata

Рис. 7. Ixodes ricinus
Бабезіоз реєструється у пасовищний
період. Перші випадки захворювання спостерігають навесні, приблизно через 2
тижні після виявлення на тваринах кліщів переносників. Найбільша кількість
хворих припадає на травень-червень і серпень-вересень, що пов’язано з
максимальною активністю членистоногих. Біотопами кліщів є вологі, порослі
чагарником луки. Швидкому розвитку й розмноженню кліщів, а відповідно і
поширенню бабезіозу сприяють дощова погода і наявність на пасовищах дрібних
ссавців - годувальників переносників збудників хвороби.
Клінічні ознаки. Інкубаційний період
становить 1-2, іноді до 3 тижнів. Перебіг хвороби гострий і починається з
різкого підвищення температури тіла до 41-42°С. У великої рогатої худоби
спостерігаються пригнічений стан, прискорення пульсу до 100-120 ударів і
дихання до 70-80 рухів за хвилину. Сеча на 2-3-тю добу хвороби набуває
рожевого, а потім темно-червоного кольору. Сечовиділення стає утрудненим,
болісним, сеча виділяється невеликими порціями, при сечовиділенні тварина
вигинає спину. Молочна продуктивність знижується на 40-80%, молоко набуває
червонуватого відтінку і стає гірким на смак. Порушується функція органів
травлення. Спочатку відмічають пронос, який змінюється стійкою атонією. Фекалії
сухі, зі слизом, іноді з домішками крові. Слизові оболонки на початку хвороби
гіперемійовані, а потім стають анемічними й жовтяничними. Кров водяниста, у ній
значно зменшується вміст гемоглобіну і кількість еритроцитів. Спостерігається
анізоцитоз, пойкілоцитоз, базофільна зернистість в еритроцитах,
поліхроматофілія і лейкоцитоз. У корів можуть траплятися аборти. За період
хвороби тварини слабнуть, корови припиняють лактацію, втрачають апетит,
з'являється гіпотермія, припиняється жування, тварини гинуть у стані повної
депресії через 3-5 діб. Летальність досягає 60%.
Лабораторні дослідження. У мазках
крові, а також у відбитках з паренхіматозних органів трупів, зафарбованих за
методами Романовського чи Паппенгейма, в еритроцитах виявляють типові форми
збудника хвороби. Високоефективними є також серологічні методи діагностики
(РЗК, РІФ, РНГА, ELISA).
Бабезіоз потрібно диференціювати від
анаплазмозу, сибірки, лептоспірозу, пастерельозу, хронічної гематурії, отруєнь
мінеральними речовинами.
Патологоанатомічні зміни. Трупи
тварин виснажені. Слизові оболонки та підшкірна клітковина бліді й жовтяничні.
Скелетні м’язи в’ялі. Кров водяниста, згортається погано. Серозні оболонки
внутрішніх органів жовтяничні, з масовими крапчастими крововиливами. В грудній
порожнині міститься 2-4 л транссудату червонуватого кольору. Легені в стані
гіперемії і набряку, в бронхах знаходиться піниста рідина (рис. 8).

Рис. 8. Гіперемія легень ВРХ.

Рис. 9. Крововиливи в нирці великої
рогатої худоби.
Слизова оболонка сечового міхура
бліда, з дрібними крововиливами, сеча світло- або темно-червоного кольору.
Лімфатичні вузли збільшені в об’ємі, соковиті на розрізі, червонуватого
кольору. Книжка заповнена сухими кормовими масами. Слизові оболонки сичуга і
кишок набубнявілі, гіперемійовані, з крововиливами.
.2 Бабезіоз дрібної рогатої худоби
Хвороба спричинюється одноклітинними
організмами Babesia ovis і B. motasi (син. Piroplasma ovis). Збудники
локалізуються в еритроцитах. Хворіють вівці, кози, архари, муфлони.
Характеристика збудників. В
еритроцитах B. оvis має кулясту, овальну, еліпсоподібну, грушоподібну форми
(рис. 10). Розміри залежно від форми паразита становлять 1-2,5 мкм (менші за
радіус еритроцита). Типова форма - парногрушоподібна, причому груші з’єднані
вузькими кінцями під тупим кутом. Положення їх в еритроциті периферичне або
центральне. Грушоподібні паразити, особливо парні, трапляються рідко,
переважають кулясті форми. Інвазованість еритроцитів досягає 45%.

Рис. 10. Babesia bovis ДРХ.
. motasi - найбільший з усіх
внутрішньоеритроцитарних паразитів дрібних жуйних тварин. Переважають кулясті,
овальні, амебоподібні, грушоподібні форми (рис. 11). За розміром вони більші
від радіуса еритроцита (2,5-4 мкм). Типовою діагностичною формою вважається
парногрушоподібна. Паразити з’єднані вузькими кінцями під гострим кутом і
розміщені в центрі еритроцита. В одному еритроциті може міститися від 1 до 4
збудників. Паразитемія сягає 20%.

Рис. 11. Piroplasma ovis.
Методи діагностики. Епізоотологічні
дані. До збудників сприйнятливі вівці й кози усіх порід та віку, але досить
тяжко хворобу переносять дорослі тварини. Ягнята й козенята, як правило,
переносять інвазію легко, часто безсимптомно. Поширення бабезіозу серед овець і
кіз пов’язане з біотопами двохазяїнних кліщів Rhipicephalus bursa (рис. 5).
Експериментально доведена можливість перенесення інвазії кліщами I. persulcatus
і D. Marginatus (рис. 12).

Рис. 12. Dermacentor marginatus
Хвороба часто реєструється в Криму.
Захворювання тварин розпочинається наприкінці квітня і триває до вересня, але
пік інвазії припадає на червень-липень, що збігається з найвищою активністю
кліщів-переносників. Можливі спалахи захворювання і у вересні - жовтні, що
пов’язують з нападами кліщів роду Dermacentor та личинок Rh. bursa. Тварини, що
перехворіли на бабезіоз, залишаються паразитоносіями понад 2 роки, а кліщі
передають збудників інвазії трансоваріально впродовж 56 поколінь. При цьому
одноклітинні організми не втрачають своєї патогенності.
Клінічні ознаки. Клінічні прояви
бабезіозів, спричинюваних B. ovis і B. motasi, подібні. Нерідко спостерігається
змішана інвазія.
Інкубаційний період триває 1-2
тижні. Захворювання починається з різкого підвищення температури тіла до 42°С і
вище і зберігається на такому рівні протягом усієї хвороби. Апетит спочатку
погіршується, потім повністю зникає. Загальний стан пригнічений. Прискорюються
пульс і дихання. Слизові оболонки на початку хвороби гіперемійовані, на 2-3-тю
добу бліднуть і стають жовтяничними. З’являється кривава сеча. Розвивається
атонія передшлунків. Хворі тварини відстають від отари, залежуються, можливе
м’язове тремтіння, парези кінцівок. У кітних вівцематок трапляються аборти, а у
лактуючих - зменшується або припиняється лактація. Гематологічними
дослідженнями виявляється різке зниження вмісту гемоглобіну, кількості
еритроцитів і лейкоцитів. Спостерігається анізопойкілоцитоз. Гострий перебіг
хвороби триває 5-7 діб, і 60-80% тварин гине з явищами набряку легень і розладу
діяльності серцево-судинної системи.
Лабораторні дослідження. Аналогічні
до тих, які проводяться при бабезіозі ВРХ. Бабезіоз дрібної рогатої худоби
потрібно диференціювати від лептоспірозу, сибірки, тейлеріозу, анаплазмозу.
Патологоанатомічні зміни. Трупи
тварин, що загинули від бабезіозу, виснажені. Слизові оболонки, підшкірна
клітковина, серозні покриви жовтяничні. Легені в стані набряку, з крапчастими
крововиливами. В трахеї та бронхах - піниста рідина. Серце збільшене, на епі-
та ендокарді - крововиливи. Селезінка збільшена, пульпа кров’яниста,
розм’якшена, темно-червоного кольору. Печінка збільшена, повнокровна,
буро-червоного кольору, з крапчастими крововиливами. Нирки збільшені, на їхній
поверхні також крововиливи, межі кіркового й мозкового шарів згладжені.
Лімфатичні вузли збільшені, соковиті на розрізі, з крововиливами. Книжка
наповнена сухими кормовими масами. Слизові оболонки сичуга, кишок набряклі,
вкриті слизом, з численними крапчастими і плямистими крововиливами.
1.3 Бабезіоз коней
Хворобу спричинюють найпростіші
Babesia caballi і B. equi, що локалізуються в еритроцитах. Крім коней хворіють
також осли та мули.
Характеристика збудників. Babesia
caballi (син. Piroplasma caballi) в еритроцитах може бути овальної, кулястої,
амебо- чи грушоподібної форми (рис. 13). Типова форма - парногрушоподібна.
Паразити розміщені в центрі еритроцита, з’єднуються загостреними кінцями під
гострим кутом; їх розміри - 2,5-4 мкм, тобто більші за радіус еритроцита. В
одному еритроциті може міститися 1-2 паразити. Їх ураженість сягає 6-10%.

Рис. 13. Piroplasma caballi
. equi (син. Nuttallia equi) має
значний поліморфізм. В еритроцитах трапляються округлі, кільце-, грушоподібні
форми, однак характерною є хрестоподібна, що нагадує "мальтійський
хрест", який утворюється при поділі збудника брунькуванням (рис.14).
Розміри бабезій коливаються в межах від 1 до 4 мкм. Наявність великих форм збудника
(більших за радіус еритроцита) свідчить про гострий перебіг хвороби. В міру
одужання тварин одноклітинні організми стають усе меншими, а при
паразитоносійстві в крові виявляють дрібні їх форми. Збудником хвороби
уражується 30-60% еритроцитів.
Рис. 14. "Мальтійський
хрест" B. equi.
Методи діагностики. Епізоотологічні
дані. Коні в молодому віці хворіють на бабезіоз у легкій формі. Тяжкий
клінічний перебіг спостерігається у тварин 2-3-річного віку і старших. Біологічними
переносниками збудників у зонах Полісся й Лісостепу України є кліщі Dermacentor
pictus і D. Marginatus (рис. 12). Спалахи хвороби найчастіше спостерігаються
навесні та восени, у період масового нападу на тварин іксодових кліщів для
кровоссання. У південних областях бабезії непарнокопитих передають кліщі
Hyalomma plumbeum (рис. 15), H. scupense, Rhipicephalus bursa (рис. 5). Тут
хворобу реєструють переважно влітку.

Рис. 15. Hyalomma plumbeum.
Клінічні ознаки. Інкубаційний період
триває 1-2 тижні. Перебіг хвороби частіше гострий, а при інвазії збудником B.
equi може бути підгострий та хронічний. Першими ознаками бабезіозу є підвищення
температури тіла до 41-42°С. Порушується діяльність серцево-судинної системи (пульс
80-100 ударів за хвилину, серцевий поштовх посилений), прискорюється дихання.
Тварини стають пригніченими, швидко втомлюються, різко знижується апетит.
Видимі слизові оболонки гіперемійовані, потім стають анемічними й жовтяничними,
зі смугастими та плямистими крововиливами. Порушується діяльність травного
каналу, що супроводжується метеоризмом і коліками. Гемоглобінурія
спостерігається рідко, але сеча набуває темно-жовтого кольору, стає каламутною.
У кобил можливі аборти. Зміни в крові наступають швидко і повільно
відновлюються, іноді протягом 1-1/2 місяців. Кількість еритроцитів падає до 3
мільйонів і нижче в 1 мм3, гемоглобіну - до 30-25%; РОЕ різко
прискорюється; визначається анізоцитоз і рідше - пойкілоцитоз. В білій крові
відзначають нейтрофільний зсув вліво і моноцитоз до 10-20%, який утримується
від 6 до 30 днів. У 50% хворих, поряд з моноцитозом, буває помірний лімфоцитоз.
Лужний резерв крові падає. При наростанні клінічних ознак тварини гинуть
упродовж першого тижня хвороби. Смертність коней може сягати 30-40%.
За підгострого та хронічного
перебігу бабезіозу клінічна картина менш виражена. Інкубаційний період триває
близько 1 міс. Температура тіла не піднімається вище 40°С. Апетит часто
зберігається. Зміни в крові менш виражені, наступають пізніше (на 10-12-й день)
і довгостроково утримуються без особливих коливань. Хвороба триває від 1 до 3
місяців і при поліпшенні умов утримання й годівлі закінчується одужанням.
Лабораторні дослідження. Аналогічні
до тих, які проводяться при бабезіозі ВРХ. Бабезіоз непарнокопитих потрібно
диференціювати від інфекційної анемії. Патологоанатомічні зміни. Слизові
оболонки блідо-жовтяничні (рис. 16).

Рис. 16. Крововиливи в слизовій
оболонці носа коня.
Селезінка збільшена, повнокровна, з
крапчастими крововиливами. Печінка збільшена, часто має глинистий колір (рис.
17).

Рис. 17. Печінка хворого на бабезіоз
коня.
Нирки збільшені (рис. 18), сеча
каламутна, іноді червоного кольору.

Рис. 18. Гемосидероз і крововиливи в
нирках коня.
.4 Бабезіоз свиней
Хвороба свійських і диких свиней,
спричинювана одноклітинними організмами Babesia trautmanni і B. perroncitoi.
Характеристика збудників. Babesia
trautmanni - поліморфний паразит порівняно великих розмірів, найбільше подібний
до збудника бабезіозу собак. В еритроцитах бабезії бувають овальної, кільце-,
амебо-, грушо-, парногрушоподібної форми. Типова форма парногрушоподібна,
паразити, розміщені в центрі еритроцита, з’єднуються тонкими кінцями під
гострим кутом, розмір їх більший за радіус еритроцита. В одному еритроциті може
міститись до 8 бабезій. Їх ураженість сягає 65%.. perroncitoi порівняно з
попереднім видом - дрібний паразит. В еритроцитах трапляються переважно
кільцеподібні форми діаметром 0,5-2 мкм. Ураженість еритроцитів невисока.
Методи діагностики. Епізоотологічні
дані. Джерелом інвазії є хворі й перехворілі тварини, які залишаються
паразитоносіями. Хвороба поширена в багатьох країнах, бабезіоз свиней реєстрували
й в Україні. Хвороба сезонна і проявляється у весняно-літній період у тварин,
яких випасають на пасовищі. Найбільш сприйнятливі до збудників поросята
2-4-місячного віку. Поширення інвазії серед свиней пов’язане з ареалом
кліща-переносника Rhipicephalus turanicus, з трансоваріальним типом циркуляції
збудника в ньому.
Клінічні ознаки. Інкубаційний період
триває 12-15 діб. Перебіг хвороби гострий. У хворих тварин температура тіла
підвищується до 41-42°С. Вони відмовляються від корму, на пасовищі відстають
від гурту, в станках забиваються у найменш освітлений куток (світлобоязнь),
стають малорухливими. Пульс і дихання прискорюються, порушується робота
травного каналу (запор чергується з проносом). Слизові оболонки спочатку
гіперемійовані, пізніше бліднуть і набувають жовтого забарвлення. Шкіра також
жовтіє. Свині худнуть. На 3-4-ту добу в них з’являється гемоглобінурія.
Супоросні свиноматки абортують. Швидко прогресує анемія. Кров стає водянистою,
в ній різко знижуються вміст гемоглобіну і кількість еритроцитів. У деяких
тварин може спостерігатися скреготання зубами, спотворений апетит, агресивність
- хворі з люттю кидаються на людей і тварин. Летальність сягає понад 50%.
Лабораторні дослідження. У мазках
крові, виготовлених з периферичних судин вушної раковини чи кінчика хвоста,
пофарбованих за методами Романовського чи Паппенгейма, в еритроцитах виявляють
збудників хвороби.
Патологоанатомічні зміни. Трупи
свиней, що загинули від бабезіозу, виснажені. Шкіра, видимі слизові оболонки,
підшкірна сполучна тканина, серозні оболонки жовтяничні. Лімфатичні вузли
збільшені, соковиті на розрізі, гіперемійовані, з крововиливами. Серцеві м’язи
бліді, кольору вареного м’яса. Під епі- та ендокардом - численні крововиливи.
Селезінка збільшена, пульпа розм’якшена. Печінка збільшена, в’яла, на розрізі
соковита, малюнок згладжений. Жовчний міхур розтягнутий, заповнений густою
жовчю. Нирки набряклі, гіперемійовані, капсула знімається легко, під нею
місцями крововиливи. Сечовий міхур заповнений сечею від рожевого до темнокоричневого
кольору, слизова оболонка його набубнявіла, жовта. Слизова оболонка шлунка й
кишок катарально запалена, з численними крапчастими крововиливами у
підслизовому шарі.
.5 Тейлеріоз великої та дрібної
рогатої худоби
Збудниками тейлеріозу у великої рогатої
худоби є Theileria annulata, Th. parva, Th. mutans, у овець і кіз - Th. ovis і
Th. hirci. Локалізуються вони в клітинах системи мононуклеарних фагоцитів
лімфатичних вузлів, селезінки, печінки, кісткового мозку, а також в еритроцитах
і лейкоцитах.
Характеристика збудників. Морфологія
збудників залежить від їхньої стадії розвитку. У перші дні хвороби виявляють
так звані "гранатні тіла" тільки в мазках, виготовлених із пунктату
лімфатичних вузлів, печінки або селезінки. У препаратах, забарвлених за методом
Романовського, це клітини завбільшки від 8 до 20 мкм, з цитоплазмою голубого
кольору і значною кількістю (15-40 і більше) темно-червоних ядер різноманітної
форми. На 2-гу-3-тю добу хвороби, а іноді пізніше, у мазках крові виявляють
еритроцитарні форми тейлерій (мерозоїти). Вони бувають кулястої, овальної,
паличко-, комо-, хрестоподібної форми, однак переважають кулясті та овальні.
Розміри мерозоїтів становлять від 0,5 до 2,5 мкм. В одному еритроциті виявляють
від 1 до 7 паразитів. Цитоплазма їх забарвлюється у голубий, ядро - у червоний
колір. Ураженість еритроцитів сягає 80-95% (рис. 19).

Рис. 19. Форма збудників
тейлеріозів.
Методи діагностики. Епізоотологічні
дані. Тейлеріоз великої та дрібної рогатої худоби дуже поширений на півдні
Росії, у державах Середньої Азії, Казахстані, на Кавказі, а також у Туреччині,
Ірані, Сирії, Китаї, Кореї, Болгарії, у багатьох країнах Африки, Азії,
Латинської Америки.
Джерелом інвазії є хворі тварини і
тейлеріоносії. Хворіють усі породи великої та дрібної рогатої худоби,
сприйнятливі також буйволи. Переносниками збудників великої рогатої худоби є
кліщі роду Hyaloma (H. anatolicum, H. detritum, H. scupense).
На тварин кліщі нападають в усіх
активних фазах розвитку. Їх біотопами є степові та передгірні цілинні пасовища.
Ці кліщі зимують у приміщеннях, тому не виключена можливість захворювання
худоби на тейлеріоз не тільки у пасовищний, а й у стійловий період. Максимальну
кількість хворих тварин реєструють в червні-липні, що пов’язано з найвищою
активністю імаго кліщів-переносників (H. anatolicum і H. detritum).
Переносниками тейлерій овець є
іксодові кліщі Haemаphуsalis sulcata (рис. 20), Ixodes persulcatus, Dermacentor
marginatus (рис. 12), а також кошарний кліщ (Alveonasus lahorensis) (рис. 21).
Сезонність і динаміка тейлеріозу визначаються видовим складом переносників, їх
біологічними особливостями, погодними умовами.

Рис. 20. Haemаphуsalis sulcata

Рис. 21. Alveonasus lahorensis
Клінічні ознаки. Перебіг хвороби
гострий і підгострий. Інкубаційний період при зараженні через укус
кліщів-переносників триває 6-12 діб. Першою ознакою хвороби у великої рогатої
худоби є різке збільшення і болючість регіонарних лімфатичних вузлів (колінної
складки, пахових, надвим’яних, передлопаткових), що розміщені по ходу
лімфатичних судин від місця прикріплення кліщів (рис. 22).

Рис. 22. Збільшення лімфатичних
вузлів:
а - підклубового (колінної складки),
б - поверхневих привушних.
Через 2-3 доби температура тіла
підвищується до 41-42°С і утримується на такому рівні 5-10 діб. Загальний стан
тварин у перші дні хвороби може бути задовільний, але вже через 3-4 доби
відмічають загальне пригнічення, зниження або повну відсутність апетиту,
припиняється жуйка, з’являється запор. Лактація у корів різко знижується або
зовсім припиняється. Видимі слизові оболонки спочатку гіперемійовані, потім
стають анемічними, іктеричними, з численними крововиливами. Іноді набрякають
повіки й з’являється сльозотеча (рис. 23). У сльозах зі слідами крові можна
виявити меронти тейлерій.

Рис. 23. Гнійні виділення з очей
корови.
Спостерігаються крововиливи на
непігментованих ділянках шкіри (вим’я, мошонка, внутрішня поверхня вушних
раковин). Хворі тварини переважно лежать, не реагують на зовнішні подразнення,
голова завернута набік. Нерідко тільні корови абортують. Різко прискорюється
пульс (80-130 ударів) і дихання (40-80 дихальних рухів) за хвилину. При
дослідженні крові відмічають еритропенію, гемоглобінемію, лейкоцитоз. У
лейкограмі спостерігають зрушення ядра вліво до юних форм і мієлоцитів. Часто
виявляють нормобласти, еритроцити з базофільною зернистістю, розвиваються
анізоцитоз, пойкілоцитоз і поліхроматофілія. Виснаження і слабкість швидко
наростають і при явищах кахексії до 80% тварин гине.
У овець і кіз хвороба починається з
різкого підвищення температури тіла до 41-42°С. Тварини пригнічені, зникає
апетит і жуйка. Збільшуються лімфатичні вузли. Прискорюються пульс та дихання.
Слизові оболонки спочатку анемічні, а потім стають жовтяничними. Розвивається
запор, фекалії з домішками крові та слизу. У деяких тварин сеча набуває темного
кольору. Хвороба триває 4-12 діб і летальність сягає 50%.

Рис. 23. Гранатне тіло в крові
хворої на тейлеріоз тварини.
Патологоанатомічні зміни. Трупи
виснажені. Слизові оболонки, шкіра на непігментованих ділянках та підшкірна
клітковина жовтяничні, з крапчастими та смугастими крововиливами. Поверхневі
лімфатичні вузли збільшені, на розрізі соковиті, гіперемійовані, зі значними
крововиливами під капсулою та в паренхімі. В грудній порожнині та осерді -
невелика кількість прозорої рідини жовтого чи червоного кольору. Костальна і
легенева плеври жовтяничні, з крапчастими крововиливами. Легені анемічні,
верхівки їх емфізематозні, з крововиливами у паренхімі. Серце збільшене, м’язи
в’ялі, сірувато-жовтого кольору. На епі- та ендокарді - крапчасті й смугасті
крововиливи.
Очеревина жовтянична, часто з
крововиливами. Печінка червонокоричневого кольору, збільшена, в’яла, під
капсулою і в паренхімі - крововиливи. Жовчний міхур розтягнутий темно-зеленою
густою жовчю. Селезінка збільшена у 1,5-2 рази, розм’якшена, на розрізі
темно-вишневого кольору, з крововиливами під капсулою. Нирки збільшені, під
капсулою, а також у кірковому і мозковому шарах та на слизовій оболонці мисок -
крапчасті крововиливи. У сечовому міхурі - прозора сеча світло- або
темно-жовтого кольору. На його слизовій оболонці - крапчасті крововиливи.
Книжка заповнена сухими кормовими масами. Слизова оболонка сичуга потовщена,
набрякла, гіперемійована, з великою кількістю крапчастих або плямистих
крововиливів, виразок, вузликів. Слизова оболонка тонких і товстих кишок
набрякла, гіперемійована, вкрита слизом, з одиночними крововиливами. Для
тейлеріозу особливо характерні грануломоподібні ураження в органах. Спочатку
вони мають вигляд червоних, а пізніше сіро-жовтого або блідо-червоного кольору
горбків і плоских бляшок. На слизовій оболонці сичуга вони розпадаються з
утворенням ерозій і виразок.
2. Методи діагностики
гемоспоридіозів
.1 Зажиттєва діагностика
гемоспоридіозів
Залежно від виду та локалізації
збудника діагностику гемоспоридіозів проводять мікроскопічними й серологічними
методами.
Мікроскопічні методи досліджень. Для
виявлення збудників бабезіозу, які локалізуються в еритроцитах, роблять тонкий
мазок.
Виготовлення високоякісного мазка
крові має велике значення для достовірної діагностики кровопаразитарних хвороб.
Техніка виготовлення мазків полягає у підготовці предметних стекол,
виготовленні мазків крові, їх фіксації та фарбуванні.
Підготовка предметних стекол. Для
виготовлення доброякісного тонкого мазка потрібно мати чисті, знежирені, без
слідів кислот і лугів предметні стекла. Для цього їх миють у теплій воді з
мийним засобом (мило, пральний порошок), споліскують і кип’ятять у 2%-му
розчині соди впродовж 2-3 год. Після цього промивають у проточній воді 12 год.,
споліскують дистильованою водою, витирають насухо рушником і вміщують для
знежирення у банку з притертою кришкою у суміш Никифорова (спирт етиловий 96%-й
і ефір для наркозу в однакових кількостях) на термін не менш як 24 год. Перед
застосуванням стекла виймають із банки пінцетом і витирають чистою тканиною, що
не залишає ворсинок, утримуючи їх за ребра.
Виготовлення мазків крові. Кров у
тварин беруть із периферичних судин вушної раковини або кінчика хвоста, а у
птиці - з гребеня чи сережок. Щоб виготовити мазок, потрібно мати шліфоване
предметне скло зі зрізаними кутами. Край його має бути ідеально рівним. Кути
зрізають для того, щоб мазок крові був вужчим за предметне скло, на якому він
зроблений.
Місце взяття крові вистригають,
протирають 70%-м етиловим спиртом або спирт-ефіром. Прокол роблять стерильною
голкою чи надрізають ножицями кінчик вуха. Використовують першу краплю крові
завбільшки з просяне зерно, яку наносять на кінець знежиреного предметного
скла. Якщо крапля велика, мазок виходить товстим, нерівним і зміщується за край
скла.
Предметне скло з краплею крові
беруть у ліву руку між великим і середнім пальцями. Кінчиками великого і
вказівного пальців правої руки захоплюють ребра шліфованого предметного скла,
ставлять його спереду краплі крові під кутом 45° і рухають управо до зіткнення
з нею. При цьому крапля рівномірно розтікається по його ребру. Потім швидко і
легко, без натискання проводять ребром шліфованого скла справа наліво по
предметному, рівномірно розподіляючи по ньому кров. Мазок має закінчуватись
нерівно, так званою "мітелкою".
У теплу пору року мазки швидко
висихають на повітрі. В холодну погоду їх сушать на грілці чи стерилізаторі,
заповнених теплою водою. Під час висушування мазки слід оберігати від мух та
прямих сонячних променів. Після висушування їх підписують простим олівцем чи
голкою по товстому краю, вказуючи вид тварини, її кличку, дату виготовлення
мазка.
Мазки фіксують в одному з таких
фіксаторів: у метиловому спирті - 3-5 хв., у суміші Никифорова - 15-20 хв., в
етиловому спирті - 20 хв. Зафіксовані мазки виймають із фіксатора пінцетом і
вертикально вміщують у штатив для предметних стекол для висихання. Зафіксовані
й висушені мазки фарбують.
Фарбування мазків за методом
Романовського. Розчин фарби Романовського, що є в продажу, - концентрований.
Для отримання робочого розчину його розчиняють дистильованою водою. Оптимальне
розчинення фарби і тривалість фарбування мазків установлюють дослідним шляхом.
Для цього в трьох посудинах готують різне розчинення фарби: в першій - 1 крапля
концентрованої фарби на 1 мл. води; у другій - 2, у третій - 3 краплі. Кожним
із розчинів фарбують 5 - 6 зафіксованих мазків крові впродовж різного часу -
20, 25, 30, 35, 40 хв. Після цього мазки досліджують і визначають розчинення
фарби й тривалість, за яких отримано найкраще фарбування. Цей процес називають
титруванням фарби і визначенням експозиції.
Для фарбування мазків завжди
використовують свіжоприготовлений робочий розчин фарби із розрахунку 3-4 мл. на
один препарат. Його краще підшаровувати під скло з мазком. При цьому на
поверхні мазка не залишається мікрочасточок нерозчиненої фарби, що полегшує
мікроскопію. Після фарбування препарати промивають проточною водою, висушують
на повітрі й досліджують за допомогою імерсійної системи мікроскопа. Правильно
пофарбовані мазки мають рожевий колір з фіолетовим відтінком. Еритроцити
забарвлюються у рожевий колір, цитоплазма лімфоцитів - у синій, а їхні ядра - у
темно-фіолетовий. Цитоплазма одноклітинних організмів набуває блакитного, а
їхні ядра - темно-червоного або червоного кольору.
Фарбування мазків за методом
Паппенгейма. Для цього застосовують два барвники: фарбу Май-Грюнвальда і
Романовського. При фарбуванні цим методом мазки не фіксують, оскільки фарба
Май-Грюнвальда готується на метиловому спирті і є барвником-фіксатором.
На нефіксовані мазки наносять 2-3
мл. фарби Май-Грюнвальда на 3 хв. Після цього фарбу змивають водою, препарати
заливають свіжоприготовленим робочим розчином фарби Романовського на 15-20 хв.
Мазки промивають водою, висушують і досліджують під мікроскопом.
Серологічна діагностика дає змогу
встановити діагноз не лише у тварин з вираженими ознаками хвороби, а й у
паразитоносіїв. У лабораторіях для діагностики гемоспоридіозів застосовують
РЗК, РТЗК, РІФ, ELISA. Антигени, виготовлені зі збудників, чітко специфічні,
допомагають точно встановити діагноз.
2.2 Посмертна діагностика
гемоспоридіозів
Патологоанатомічні зміни при
гемоспоридіозі досить специфічні. При бабезіозі трупи часто виснажені, слизові
й серозні оболонки та підшкірна клітковина жовтяничні або анемічні, лімфовузли
збільшені. Селезінка різко збільшена. Сеча часто забарвлена у червоний колір. Однак
вирішальне значення у встановленні діагнозу має виявлення збудника в трупі. Для
цього в разі підозри щодо бабезіозу роблять мазки-відбитки із селезінки,
печінки, лімфовузлів, які фіксують і забарвлюють за методом Романовського.
В трупах найпростіші зберігаються
недовго і впродовж 20-30 год. руйнуються, тому лабораторні дослідження потрібно
проводити впродовж першої доби після смерті тварини.
.3 Взяття та пересилання матеріалу
для дослідження
Для дослідження в лабораторію
надсилають тонкі мазки з периферичної крові хворих тварин (по 2 від кожної),
взяті в період розвитку симптомів хвороби, тобто при підвищеній температурі і
до застосування специфічного лікування. При забої чи падежі тварини відбирають
шматочки нирок, селезінки, печінки, серця, легень, головного мозку, а також
лімфатичні вузли (матеріал беруть до настання трупного заклякання).
При виникненні підозри на тейлеріоз
у лабораторію надсилають відбитки (мазки) лімфатичних вузлів. Для серологічного
дослідження на нуталіоз та піроплазмоз надсилають сироватку крові.
3. Ветеринарно-санітарна експертиза
м’яса при гемоспоридіозі
Туші та внутрішні органи за
відсутності жовтяничності і дистрофічних змін випускають без обмеження.
При виснаженні, з наявністю
драглистого набряку в місцях відкладання жиру або в міжм’язовій тканині,
атрофії або дистрофічних змінах м'язів і ураженнях лімфатичних вузлів тушу та
внутрішні органи утилізують.
У випадку жовтяничності, що не
зникає протягом 48 год. тушу (незалежно від вгодованості) і внутрішні органи
направляють на утилізацію.
При зникненні жовтяничності протягом
48 год. тушу і внутрішні органи випускають залежно від результатів
мікробіологічного дослідження (на наявність сальмонел).
4. Профілактика та заходи боротьби
Для виникнення захворювання
гемоспоридіозами необхідна наявність трьох ланок епізоотичного ланцюга:
заражені (хворі або перехворіли) тварини, кліщі-переносники і сприйнятливі
(здорові) тварини. Якщо є заражені кліщі, то наявність інвазованих тварин не
обов'язкова, так як для збудників (за винятком тейлерій) характерна повторність
циклу в організмі переносника при харчуванні його навіть на неспецифічних
господарях.
Основні заходи боротьби з
гемоспоридіозами полягають у здійсненні комплексу організаційно-господарських
та агротехнічних заходів (проведення меліоративних робіт, організація
культурних пасовищ), спрямованих на створення несприятливих умов для розвитку
кліщів-переносників збудників гемоспоридіозів; знищенні переносників на
тваринах, у тваринницьких приміщеннях і в біотопах; дотримання ветеринарно-санітарних
вимог при комплектуванні стад, господарств поголів'ям тварин, сприйнятливих до
гемоспоридіозів, при перегоні (перевезеннях) тварин, їх утриманні на пасовищах
і в населених пунктах, застосуванні засобів хіміопрофілактики, своєчасному лікуванні
хворих тварин.
З метою запобігання виникненню
гемоспоридіозів тварин захищають від нападу на них кліщів і комах, тому в
неблагополучних місцевостях тварин не випасають, а організовують
стійлово-табірне їх утримання або випасають на культурних пасовищах, вільних
від кліщів. В тваринницьких приміщеннях, стійлах слід систематично проводити
дезінвазію.
Варто проводити окультурення пасовищ
шляхом агромеліоративних заходів (вирубка чагарників, скошування невикористаної
трави, використання отрутохімікатів). Ефективні заходи в боротьбі з кліщами -
це зміна випасних ділянок, проведена за наступними схемами. Якщо в господарстві
є вільні від кліщів та закліщовані пасовища, то вільну від кліщів територію
ділять на чотири ділянки. На кожній ділянці худобу випасають по 25 днів,
починаючи з весни. По використанню чотирьох ділянок худобу переводять на раніше
закліщовану територію, на якій худоба не була з осені минулого року, за період,
що минув з того часу, проходить більше 7 місяців. За цей термін личинки кліща
В. calcaratus, що знаходилися на ділянці, через відсутність великої рогатої
худоби не мають можливості харчуватися, і внаслідок цього основна їх маса гине.
Якщо всі випасні ділянки
закліщовані, то зміна пасовищ організується шляхом ділення території на дві
ділянки. На одній з них випасають худобу, а інша залишається вільною на цілий
рік, протягом якого вона звільняється від кліщів. З наступного року худобу
випасають на цій оздоровленій ділянці, а закліщовану площу не використовують
протягом року.
Слід враховувати можливість
паразитування кліщів на собаках, конях та інших тварин і таким чином їх
занесення на пасовища, що не використовувалися під випас великої рогатої
худоби.
Надійною профілактикою захворювання
є стійлове утримання великої рогатої худоби тварин та регулярне їх купання або
обприскування емульсіями акарицидних препаратів (перметрин, котрин, бутокс,
бензофосфат та ін.), які повторюють через кожні 9-10 днів. Здійснюють також
хіміопрофілактику бабезіозу. У неблагополучній щодо цієї інвазії місцевості на початку
спалаху бабезіозу тваринам вводять береніл або азидин, які запобігають
зараженню кровопаразитами впродовж 2-3 тижнів. Особливу увагу приділяють
профілактиці бабезіозу худоби, завезеної в ензоотичний осередок.
Основою профілактики бабезіозу овець
і кіз є випас цих тварин на культурних пасовищах, вільних від кліщів. У
гірських і передгірних районах рекомендується ранній перегін чи перевезення
овець із зимових (рівнинних) на літні (високогірні) пасовища, вільні від
іксодових кліщів. У разі неможливості організації випасання тварин на
пасовищах, вільних від кліщів, овець регулярно (через кожні 7-10 днів)
обробляють (шляхом обприскування чи купання) емульсіями або розчинами
акарицидів. З цією метою використовують перметрин, бутокс тощо. Застосовують
також метод хіміопрофілактики. Для цього при появі в отарі перших випадків
захворювання овець на бабезіоз тваринам вводять препарати диміназен ацетурату в
профілактичній дозі. За потреби їх введення повторюють через 2 тижні.
Головною метою у профілактиці
бабезіозу свиней є недопущення нападу на них кліщів-переносників (стійлове
утримання тварин, випасання свиней на вільних від кліщів пасовищах, організація
культурних пасовищ, застосування акарицидів для знищення членистоногих на
тваринах і в приміщеннях).
Для знищення іксодових кліщів на
конях у період їх масового нападу тварин один раз на тиждень обприскують або
обтирають водними емульсіями акарицидів на основі піретроїдів. Норма витрат цих
препаратів становить 2-2,5 л на одну тварину. У разі появи перших випадків
захворювання для хіміопрофілактики застосовують препарати диміназен ацетурату
З метою запобігання зараженню жуйних
тварин збудниками тейлеріозу крім стійлового утримання та випасання їх на
пасовищах, вільних від кліщів, надійним заходом є вакцинація великої рогатої
худоби. Вакцину вводять сприйнятливому молодняку підшкірно в дозі 1 мл в
осінньо-зимовий період. Імунітет утворюється на 30-35-ту добу і зберігається
все життя, якщо на тварин щороку нападають інвазовані тейлеріями кліщі. В
іншому разі імунітет зберігається до 2 років.
Тваринам, хворим гемоспоридіозами,
особливо тейлеріозом, крім лікувальних препаратів необхідно застосовувати
симптоматичні та патогенетичні засоби залежно від її стану. Симптоматичні
засоби застосовують для поліпшення діяльності серця, роботи шлунково-кишкового
тракту, а патогенетичні - для загального стимулювання організму, посилення
функції кровотворних органів.
Хворим тваринам надають спокій,
легко перетравний і якісний корм, регулярний водопій; при підвищеній
температурі тіла з раціону слід виключити концентровані корми.
Гемоспоридіози великої рогатої
худоби, овець і кіз часто реєструються у вигляді змішаних (асоціативних)
інвазій з анаплазмозом, кокцидіозом, гельмінтозами. У випадках змішаних інвазій
необхідно проводити комплексне лікування із застосуванням специфічних,
симптоматичних і патогенетичних засобів.
У період захворювання в
неблагополучних на гемоспоридіоз господарствах за всіма тваринами необхідно
встановити постійний ветеринарний нагляд. З метою своєчасного виділення хворих
тварин проводити поголовну термометрію тварин. Тварин, з підвищеною
температурою або іншими ознаками хвороби ізолюють, а коней звільняють від
роботи. Від усіх хворих тварин досліджують мазки крові на наявність
гемоспоридіозу.
Перехворілих тварин дозволяється
допускати в загальне стадо (табун) або на роботу тільки після остаточного
клінічного одужання.
Комплектування тваринницьких
господарств, що знаходяться на благополучних і загрозливих по гемоспоридіозам
територіях, тваринами з неблагополучних зон забороняється.
Поповнення тваринами господарств, що
знаходяться на загрозливих по гемоспоридіозам територіях, дозволяється тільки з
благополучних і відповідно з небезпечних, щодо гемоспоридіозів районів. Тварин,
призначених для комплектування зазначених господарств, перед відправкою слід
ретельно оглянути і в разі виявлення на них іксодових кліщів обробити
акарицидами. У період 30-денного спостереження за тваринами ветеринарні фахівці
зобов'язані регулярно проводити поголовну термометрию тварин. У разі виявлення
тварин з підвищеною температурою тіла їх ізолюють і вживають заходів до
встановлення діагнозу.
Перегін (перевезення) тварин з
неблагополучних господарств через загрозливі території. Та з неблагополучних і
загрозливих по гемоспоридіозам господарств через благополучні дозволяється
проводити лише за умови звільнення тварин, що переганяються (перевозяться), від
кліщів на місці перед відправленням і систематично на шляху прямування.
Висновки
Гемоспоридіоз - смертельно
небезпечне захворювання, яке переносить іксодовий кліщ. Хоча ця хвороба добре
вивчена та існують високоефективні засоби для лікування, гемоспоридіоз у 40-80%
випадків захворювань закінчується летально. Це зумовлено труднощами в
діагностиці інвазій. Більшість з них за клінічними ознаками подібні до
інфекційних захворювнь, що може призвести до встановлення помилкового діагнозу
хвороби і, як наслідок, - до помилок у здійсненні лікувально-профілактичних
заходів.
Виходячи з цього, лікар ветеринарної
медицини повинен комплексно підходити до встановлення кінцевого діагнозу
хвороби на підставі епізоотологічних даних, клінічних ознак хвороби,
патологоанатомічних змін та результатів лабораторних досліджень. Останні мають
вирішальне значення в підтвердженні діагнозу.
Головною метою у профілактиці гемоспоридіозу
тварин є недопущення нападу на них кліщів-переносників (стійлове утримання
тварин, випасання на вільних від кліщів пасовищах, організація культурних
пасовищ, застосування акарицидів для знищення членистоногих на тваринах і в
приміщеннях). Надійним заходом запобігання зараженню великої рогатої худоби
збудниками тейлеріозу є вакцинація. У разі появи перших випадків захворювання
застосовують засоби хіміопрофілактики. Тваринам, хворим гемоспоридіозами, крім
специфічних лікувальних препаратів необхідно застосовувати симптоматичні та
патогенетичні засоби залежно від її стану.
Список використаної літератури
1. Ветеринарні
вимоги щодо імпорту в Україну об'єктів державного ветеринарно-санітарного
контролю та нагляду (Назва із змінами, внесеними згідно з Наказом Державного
департаменту ветеринарної медицини №52 (z0813-02) від 27.09.2002).
Зареєстровано в Міністерстві юстиції України 11 листопада 1999 р. за №777/4070.
2. Ветеринарна
клінічна біохімія / Левченко В.І., Влізло В.В., Кондрахін І.П. та ін.; За ред.
В.І. Левченка і В.Л. Галяса. - Біла Церква, 2002. - С. 301-326.
3. Клінічна
діагностика внутрішніх хвороб тварин / Левченко В.І., Влізло В.В., Кондрахін
І.П. та ін.; За ред. В.І. Левченка. - Біла Церква, 2004. - 608 с.
4. Морфология,
биология и лабораторная диагностика возбудителей протозойных заболеваний
животных: учебно-методическое пособие / С.Н. Луцук, А.А. Водянов, В.П.
Толоконников и др.; Ставропольский государственный аграрный университет. -
Ставрополь: АГРУС, 2009. - 60 с.
5. Паразитологія
та інвазійні хвороби тварин: Підручник / В.Ф. Галат, А.В. Березовський, М.П.
Прус, Н.М. Сорока; За ред. В.Ф. Галата - К.: Вища освіта, 2003. - 464 с.: іл.
. Паразитологія
та інвазійні хвороби тварин. Практикум: Навч. посібник / В.Ф. Галат, А.В.
Березовський, М.П. Прус, Н.М. Сорока. - К.: Вища освіта, 2004. - 238 с.: іл.
. Правила
передзабійного ветеринарного огляду тварин і ветеринарно-санітарної експертизи
м’яса та м'ясних продуктів, затверджені наказом Державного департаменту
ветеринарної медицини України від 07.06.2002 №28 та зареєстровані у
Міністерстві юстиції У країни 21.06.2002 за №524/6812.
. Правила
відбору зразків патологічного матеріалу, крові, кормів, води та пересилання їх
для лабораторного дослідження. №15-14/111 від 15.04.1997 р.
. Практикум
по диагностике инвазионных болезней животных / М.Ш. Акбаев, К.И. Абдуладзе,
В.И. Тараканов и др. - М.: Колос, 1994.
. Степанова
Н.И. Протозойные болезни сельскохозяйственных животных/ Н.И. Степанова, Н.А.
Казаков, В.Т. Заболоцкий. - М.: Колос, 1998. - 352 с.
. Урбанович
П.П., Потоцький М.К. та ін. Патологічна анатомія тварин. Навч.посібник. - К:
Ветінфром, 2008. - 896 с., іл. 253.
12. Хоменко
В.І. Практикум з ветеринарно-санітарної експертизи з основами технології та
стандартизації продуктів тваринництва і рослинництва. - К.: Ветінформ, 1998.
13. Шевцов
А.А. Ветеринарная паразитология -3-е изд., доп. и перераб. -К.: Вища шк., 1983.
- 279 с., 22 ил.